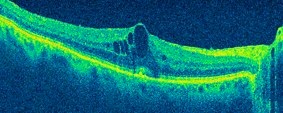
oct1

L'Ambulatorio Oculistico OCUVIS è dotato del Cirrus HD-OCT. Sviluppato dalla Carl Zeiss Meditec, la casa che per prima ha introdotto sul mercato l’OCT negli anni Novanta, il Cirrus HD-OCT rappresenta l’ultima evoluzione di tale tecnologia.
Esso consente l’acquisizione d’immagini ad altissima risoluzione (meno di 5 micron) della retina e del nervo ottico, fornendo una quantità di dati e informazioni sinora impensabili.
Le applicazioni dell’OCT (abbreviazione per Optical Coherence Tomography) e in particolare del Cirrus HD-OCT sono innumerevoli. Cliccate sui link sottostanti per vedere alcuni esempi:
|
|
 |
 |
||
| Edema Maculare Cistoide | Degenerazione maculare senile | Glaucoma |